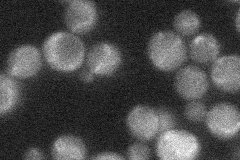
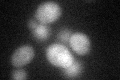

View description
Protein involved in control of cell wall structure and stress response; inhibits Cbk1p protein kinase activity; overproduction confers resistance to cell-wall degrading enzymes
Localization:
Intensity:
Fold change:
Significance:
-
C’ GFP library in SD

cytosol22.31 -
N' NOP1pr-GFP in SD

punctate,bud neck45.9326 -
N' TEF2pr-mCherry in SD

cytosol0 -
N' NATIVEpr-GFP in SD
below threshold24.7858 -
N' TEF2pr-VC and Cyto-VN in SD

#N/A0 -
C’ GFP library in SD+DTT
cytosol20.160.9No -
C’ GFP library in SD+H2O2

cytosol22.981.03No -
C’ GFP library in Starvation Media

cytosol16.770.75No -
C’ GFP library on the background of Pup2-DaMP

cytosol -
C’ GFP library on the background of CCT mutant

cytosol25.11951.1258No
